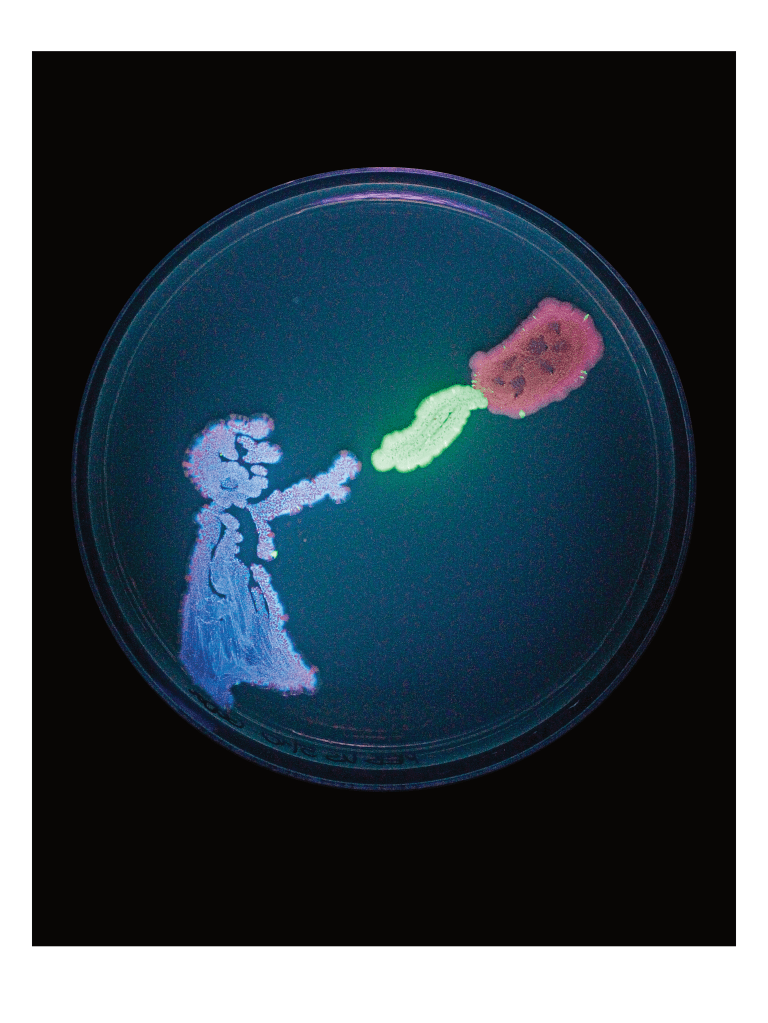
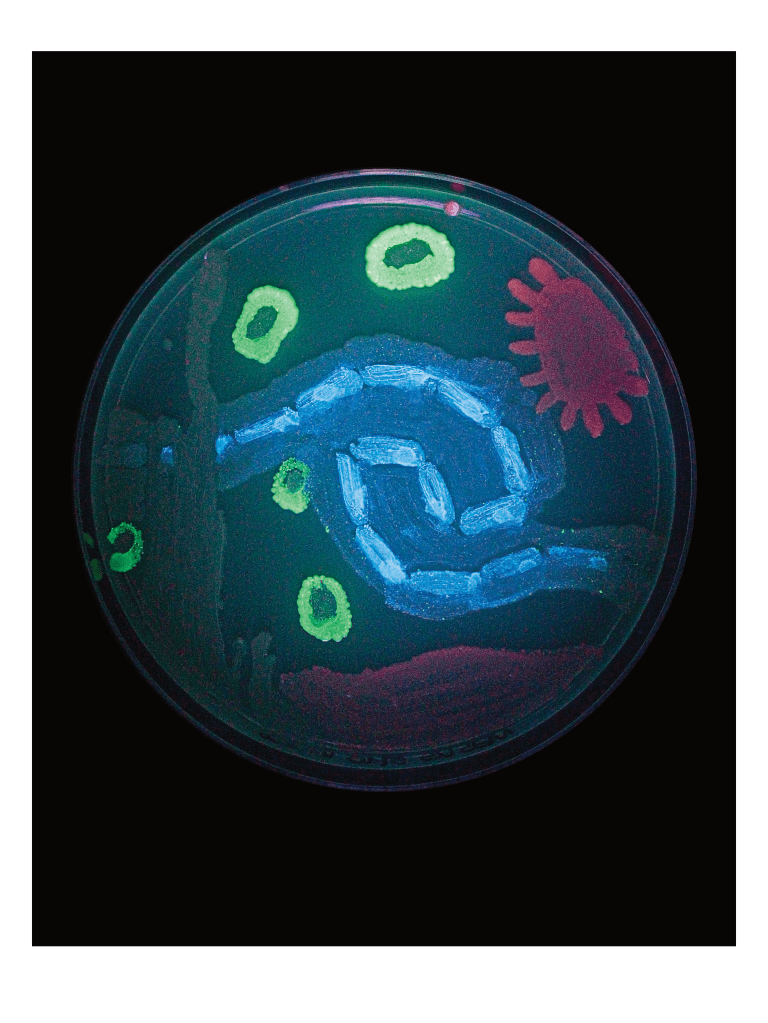
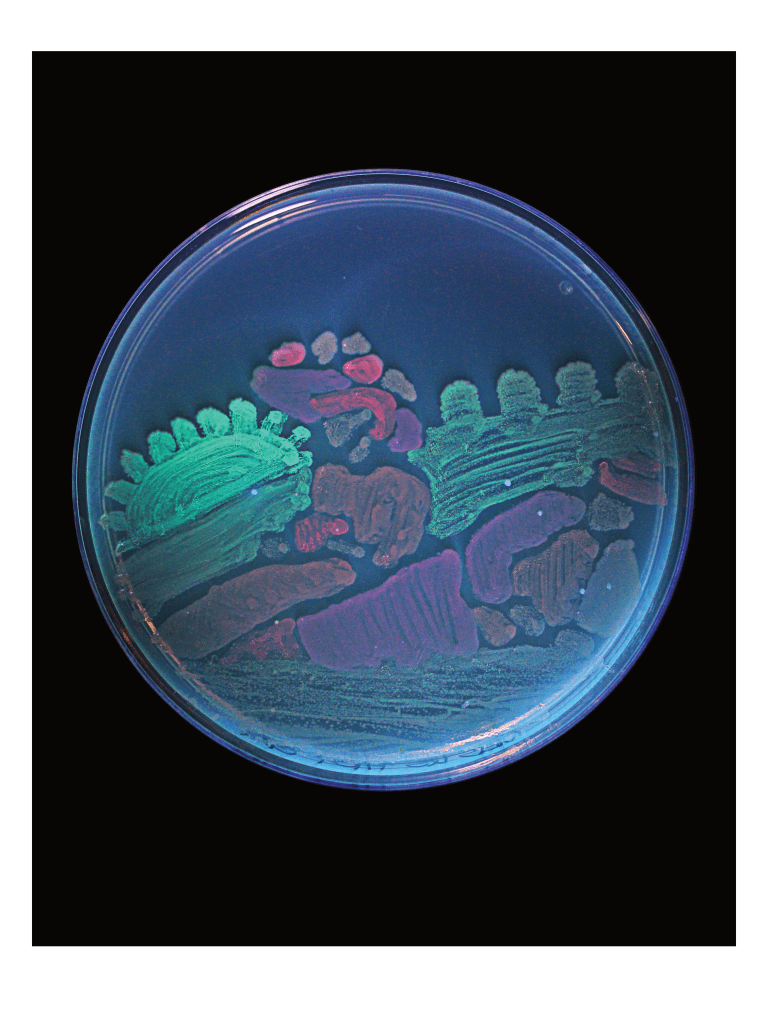
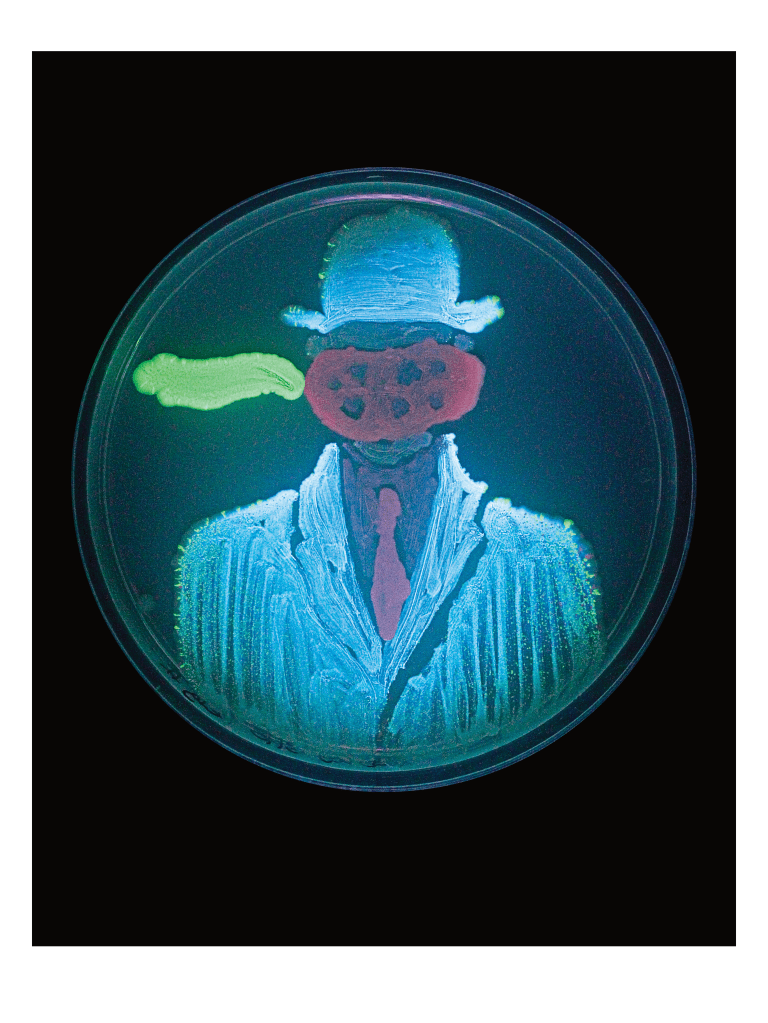
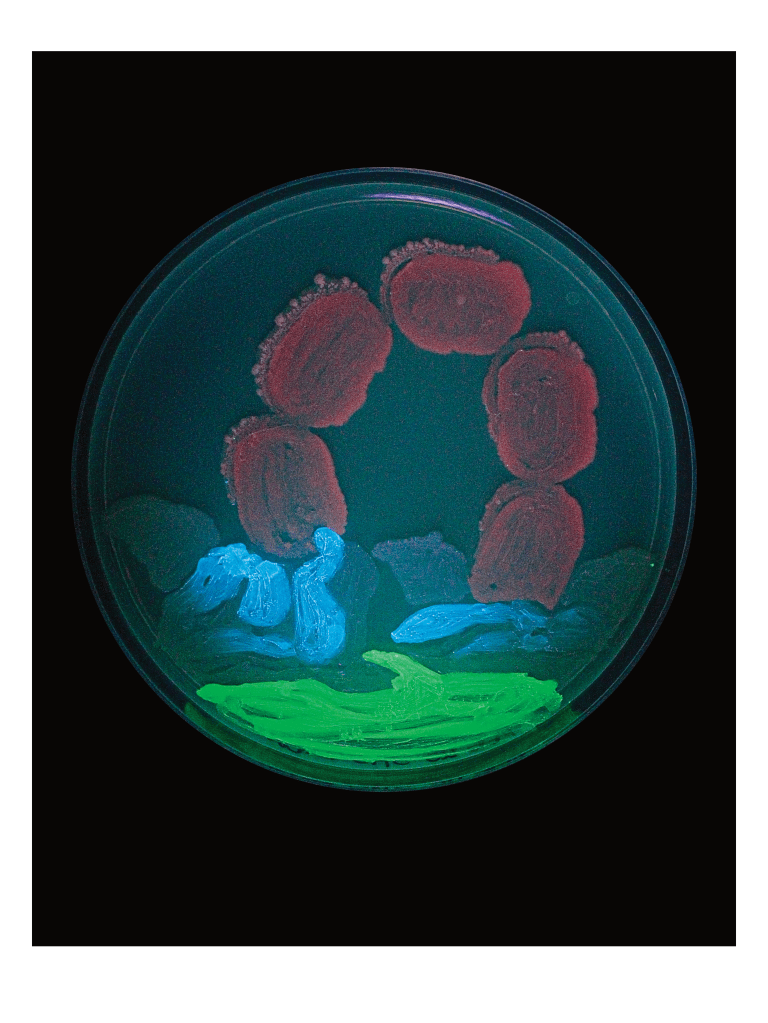
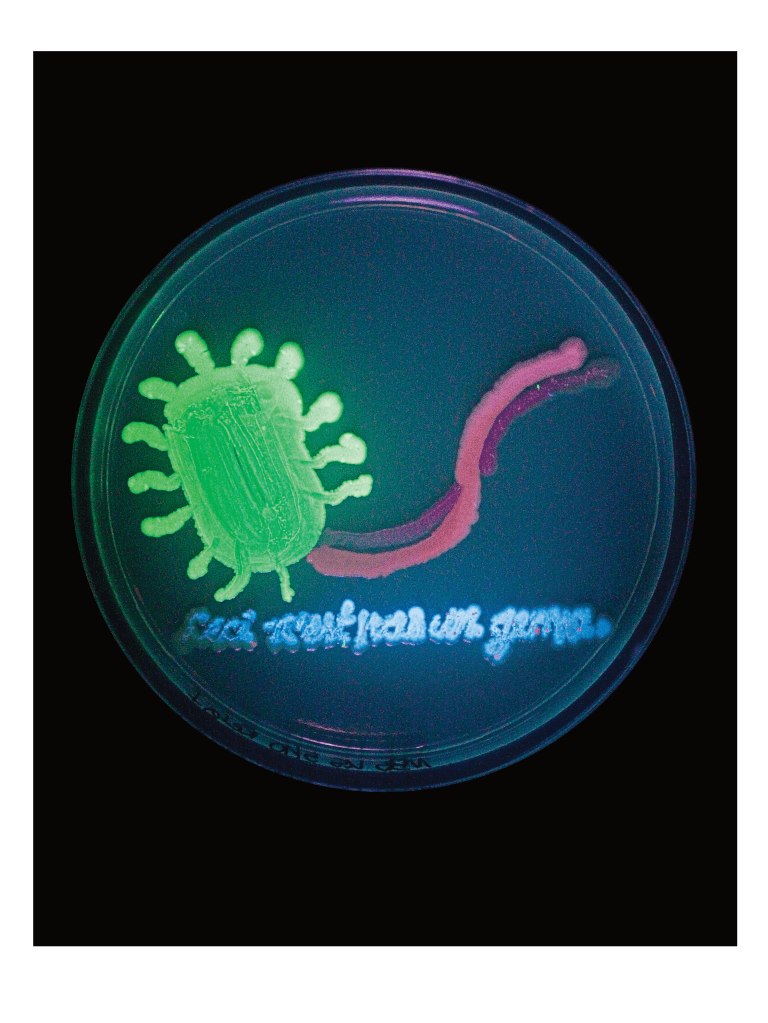
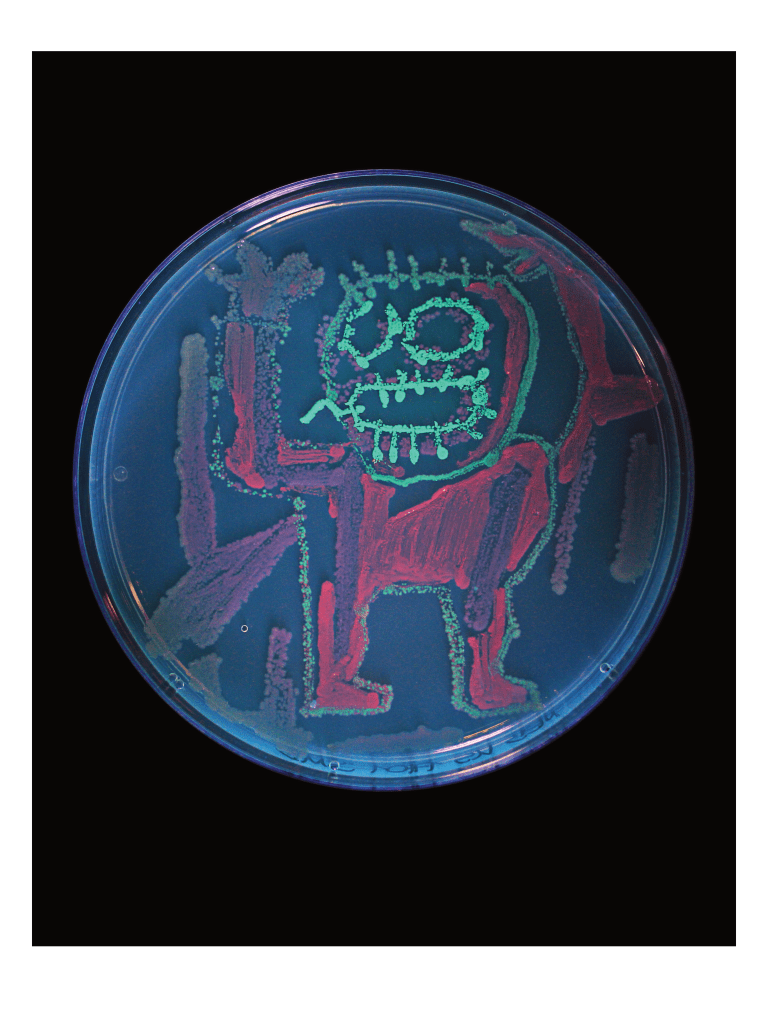
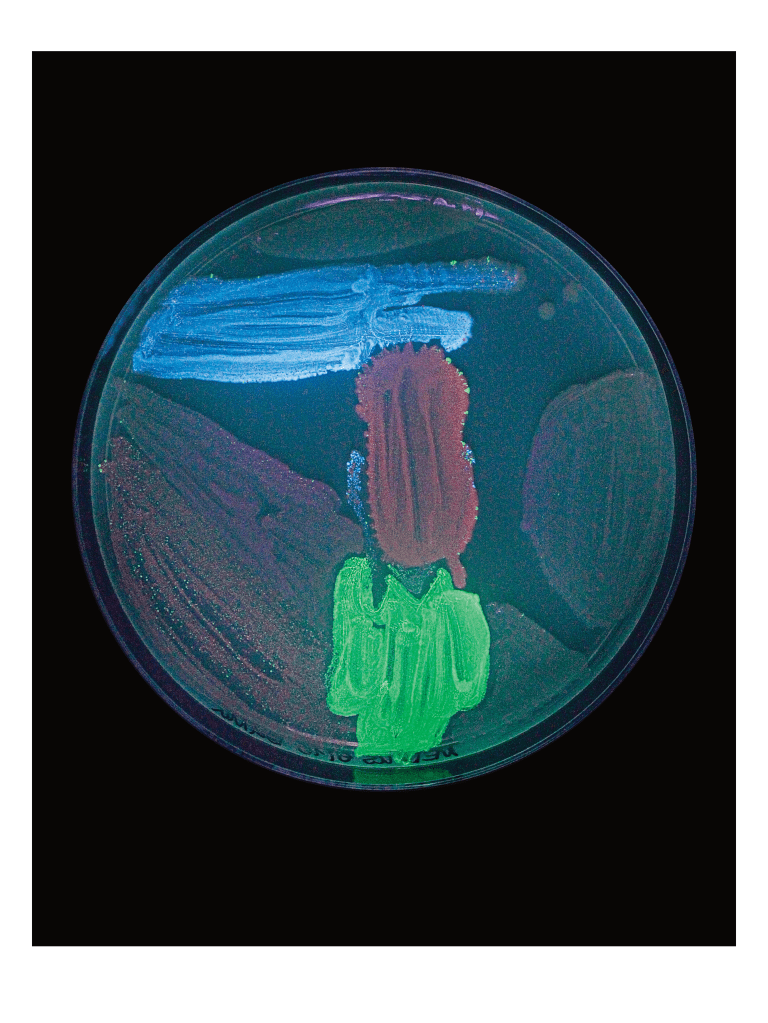
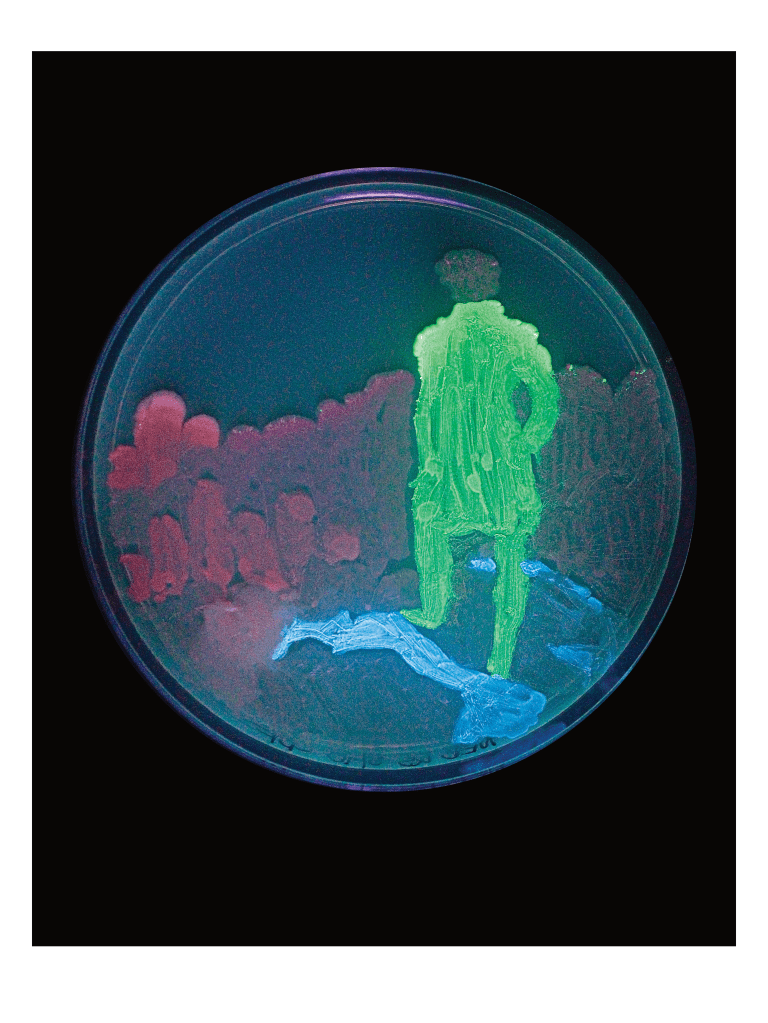
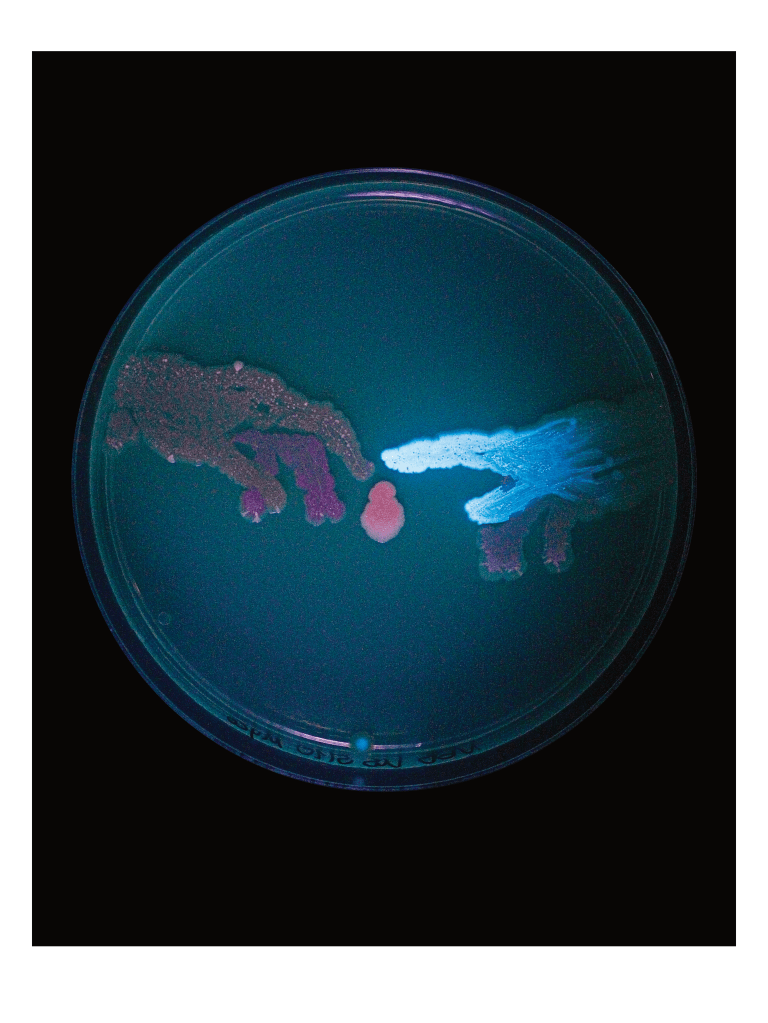
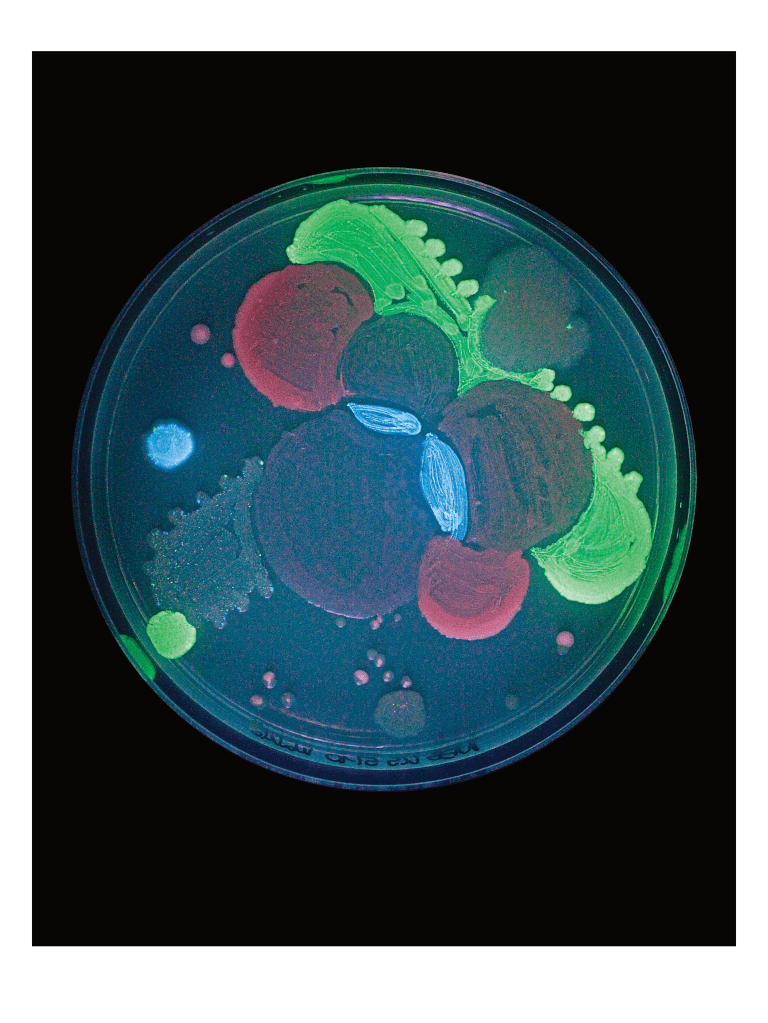
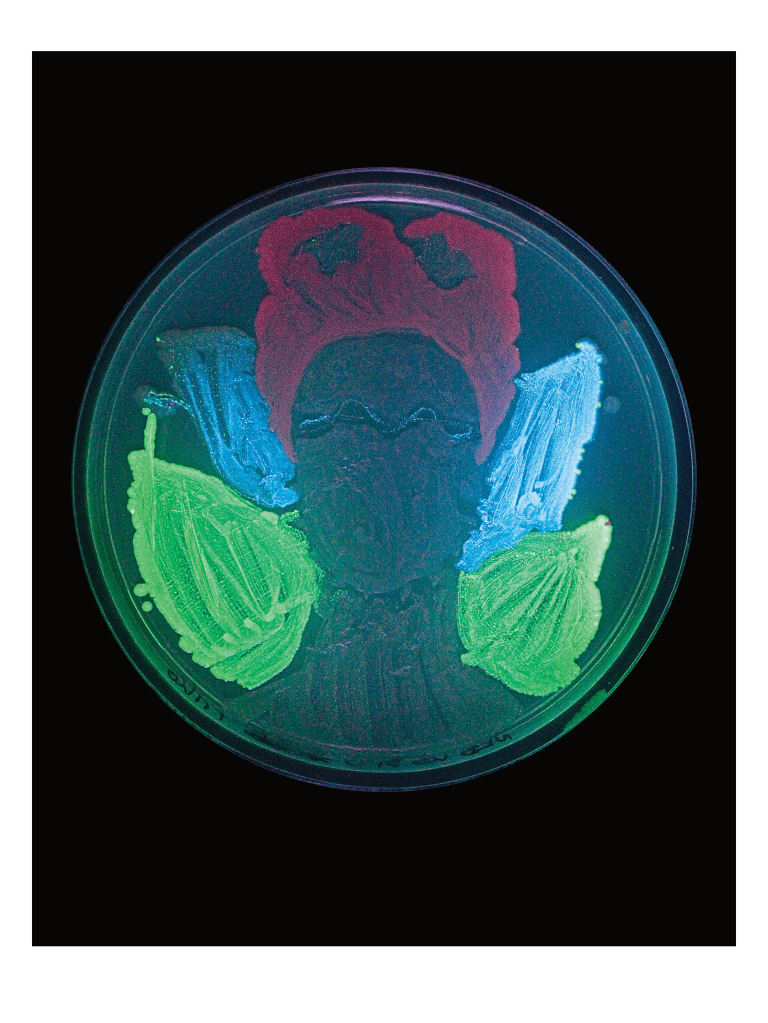
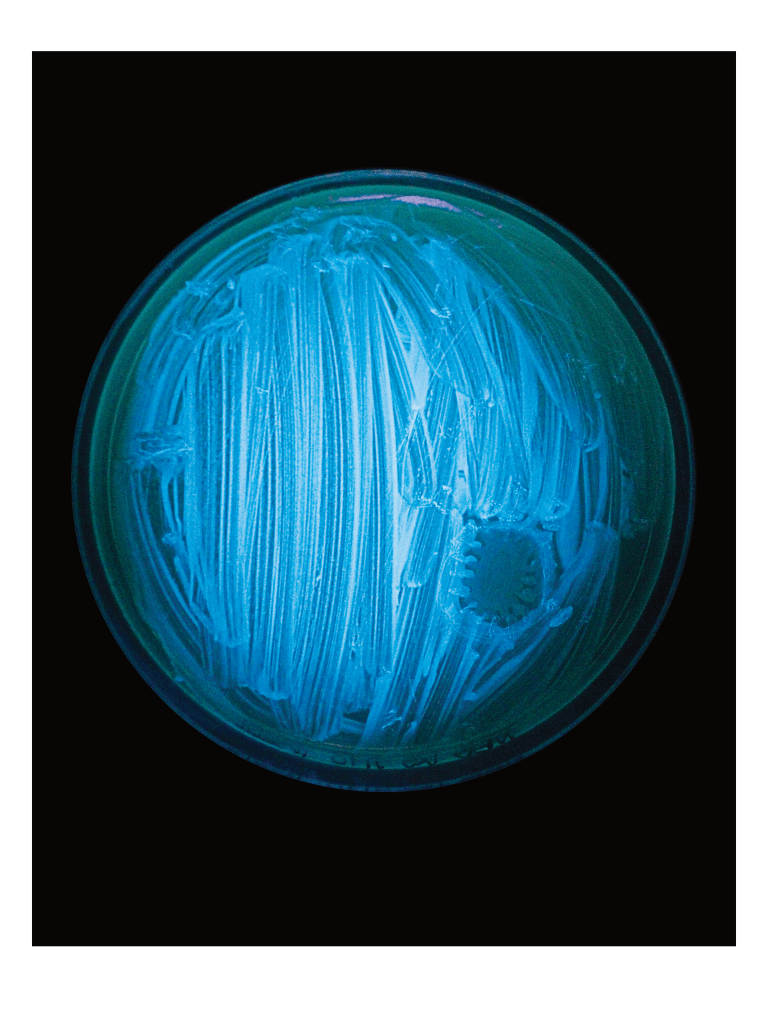

G A L E R I E
Kunst und Kultur?
Die heutige Welt ist reich an Kunst und Kultur, welche sich über Jahrhunderte hinweg entfaltet hat. Dennoch fehlt einigen Menschen leider immer noch das Bewusstsein oder der Weitblick, um bestaunen zu können, welche bemerkenswerten Entwicklungen wir als Gesellschaft durchlebt haben. Gerade die gebührende Anerkennung des Weges, den die Kunst bis zur Gegenwart zurückgelegt hat, fehlt häufig. Ziel der Reihe „Kunst und Kultur“, aus der die Werke stammen, ist es, dieser Selbstverständlichkeit entgegenzuwirken und ein Bewusstsein für den Weg vom simpelsten Lebewesen hin zu einer Gesellschaft voller Vielfalt und kreativem Wirken zu schaffen. Um dies zu erreichen, habe ich mit dem mikrobiologischen Fachbereich der Universität Osnabrück kooperiert und mit Hilfe von Bakterienkulturen, die sich durch Fluoreszenzproteine und Schwarzlicht farbig leuchtend entwickelten, mikrobiologische Hommagen an die großen Künstler*innen unserer westlichen Kunstgeschichte gemalt. Das Projekt „Kunst und Kultur“ schafft eine Brücke zwischen unserem Ursprung, unserer Schöpfung, und dem von uns Geschöpften. Und alles in Zusammenarbeit mit einer der Lebensformen, mit denen alles begann: den Einzellern.

kontakt@konstantinsauer.com
© 2025 Konstantin Sauer. Alle Rechte vorbehalten.
